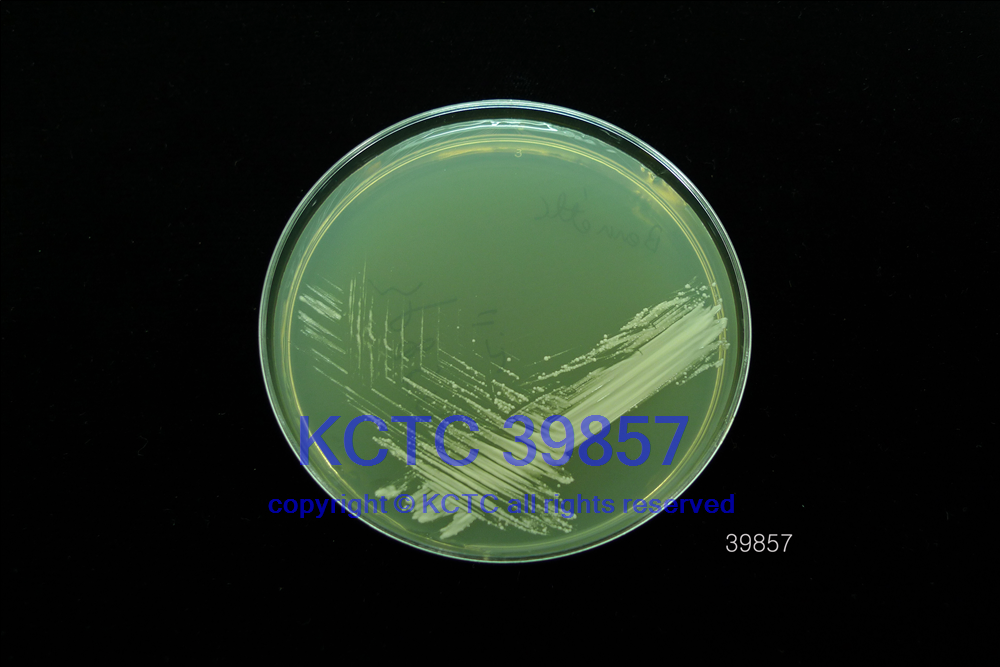

KCTC No. 39857
(KCTC Other No.)
Resource Type Bacteria
Name Corynebacterium afermentanssubsp. afermentans
Type Strain Yes
Biosafty Level 2
LMO No
Synonym
Phylum (ex Phylum) Actinomycetota (Actinobacteria)
Genome Information
NCBI Genome UID : GCA_030408355.1
JGI Genome ID : Gp0131653
History <- JCM
Source From Human blood culture, Canada
Other Collection No. JCM [10390], ATCC [51403], CCUG [32103], CIP [103499], DSM [44280], LMG [19062]
Reference 10.1099/00207713-43-2-287
KCTC Media No. KCTC media No. 225 R Agar
Oxygen Requirement Aerobic
Temperature 37 ℃
pH netural pH ?? ?? (???? ??)